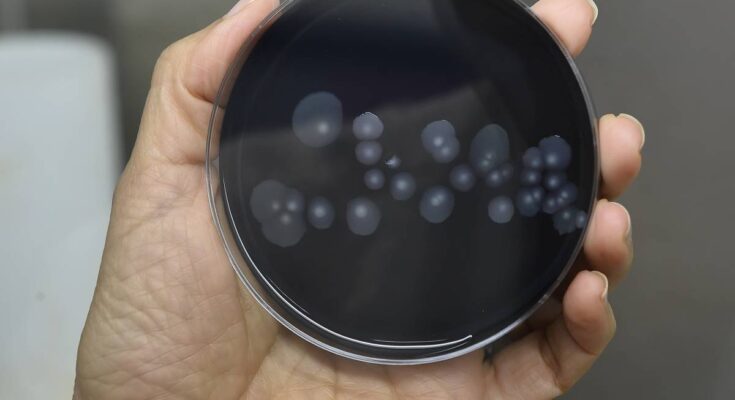

ATS Metropolitan City of Milan has communicated several cases caused by infection legionella caused by the San Siro district. There are currently eleven people infected, and unfortunately one death has been recorded as well.
Based on what has been reported so far, a suspected outbreak has been identified San Siro district in Milanprecisely in the area near Via Rembrandt. Health authorities have discovered eleven cases, all of which have elements that suggest possible legionella infection. Eight people were hospitalized due to symptoms, and one death was also recorded. This is the assessment of ATS Milan which is currently carrying out the necessary investigations.“An investigation has been launched to identify the origin of the infection by taking samples in homes, the laboratory results of which are still pending and by evaluating other sensitive places in the neighborhood.”that’s what we read in the official communication from ATS.
This is not the first time Milan has faced such problems. Last July, another one was registered in the buildings on Via Rizzoli epidemic from legionella, which has infected nine people. Unfortunately, on that occasion there was also one person who died due to infection.
But what do we know about legionella? That’s a bacteria from the aerobic gram-negative family. This pathogen is found in natural and artificial water environments, so it is not uncommon for this pathogen to spread to home water sources. Transmission occurs through aerosols, through inhalation of very small droplets. You cannot catch it from person to person, or through drinking contaminated water or food. Among them symptom we had high fever, cough, difficulty breathing and muscle aches.
In more serious cases, kidney failure or shock can also occur. Discomfort appears approximately 2-10 days after infection. Once the diagnosis is made, targeted antibiotic treatment needs to be continued, therefore it is important to undergo a medical examination immediately.